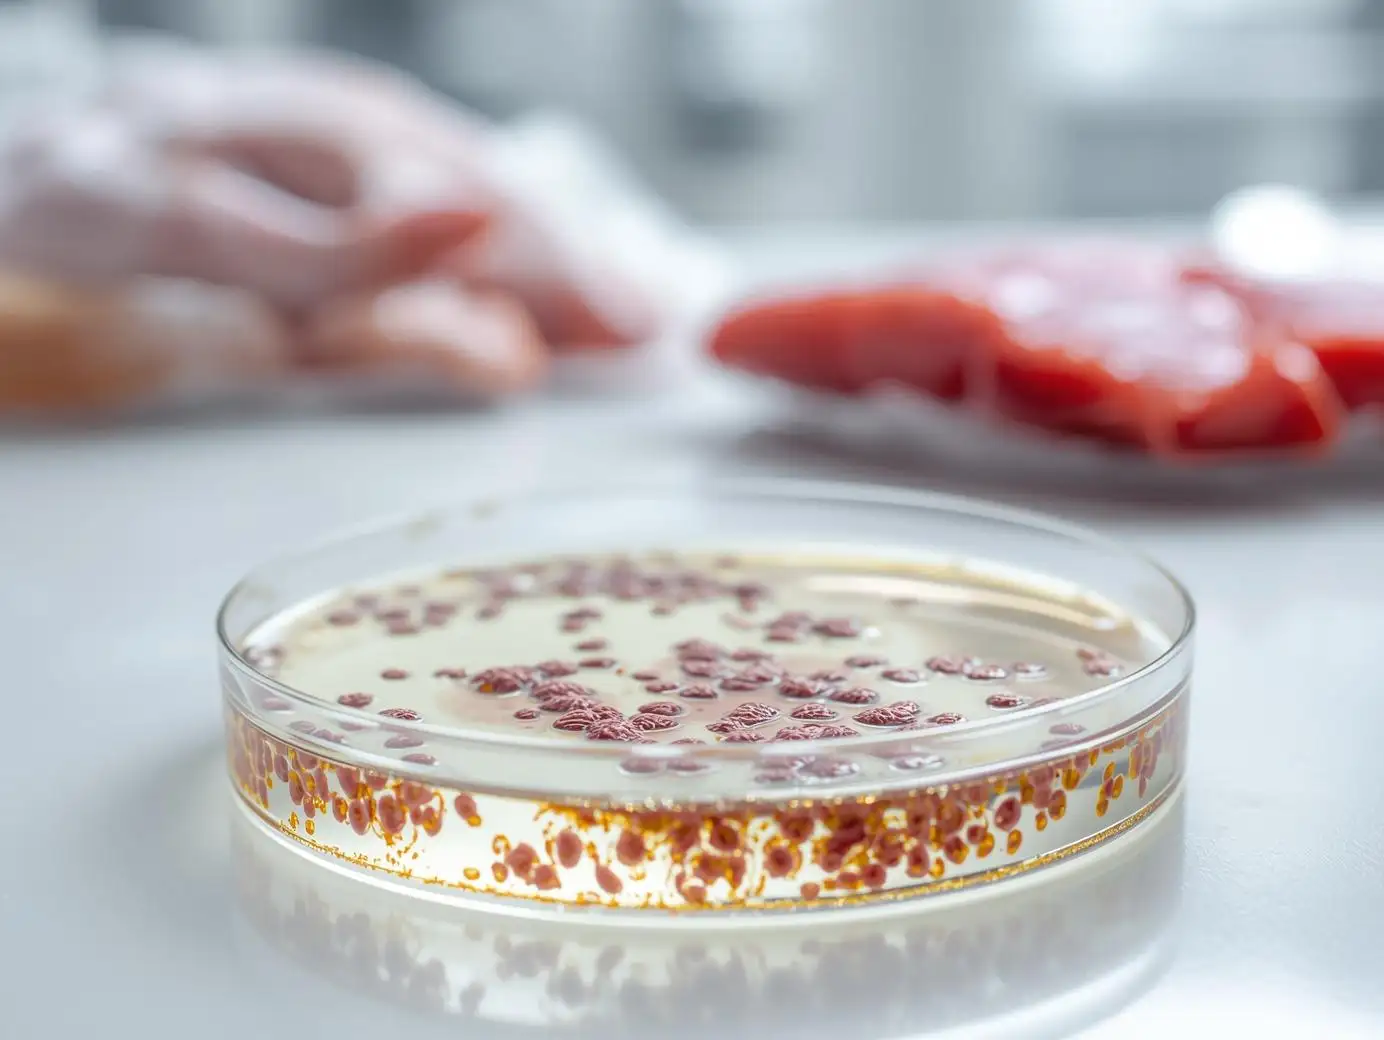
Vibrio Testing

Foodborne Pathogen Testing
& Toxin Analysis
Identify dangerous microorganisms and heat-stable toxins before they reach the consumer. AGT delivers comprehensive foodborne pathogen testing for product safety and FDA / USDA compliance.
Control of Foodborne Pathogens
Effective management of foodborne pathogens through accredited foodborne pathogen testing is the cornerstone of any modern food safety program. AGT Food Labs coordinates a full spectrum of foodborne pathogen testing covering the major bacterial pathogens, heat-stable toxins, and viral targets — helping you identify contamination risks, prevent outbreaks, and meet FDA, USDA, and FSIS standards while avoiding costly FDA import detentions.
Common Foodborne Pathogens & Toxins
High-precision detection of leading recall causes — including Salmonella and Listeria — under FSIS, FDA, and international safety standards. Comprehensive foodborne pathogen testing across the priority bacterial, toxin, and viral targets.

STEC (Shiga-toxin E. coli)
Shiga toxin-producing Escherichia coli (STEC) is a USDA zero-tolerance adulterant in raw beef. Validated PCR detection of stx1 / stx2 plus the seven serogroups (O157, O26, O45, O103, O111, O121, O145) .
- AOAC RI 121203
- PCR Molecular Detection
Sample Size: 375g (N60) or 25g | LOD: Negative per sample | Shipping: Refrigerated (2–8°C)
Industry Application:Mandatory N60 excision sampling for beef trim and ground beef compliance. Critical for agricultural water testing under FSMA for leafy greens and sprouts.

Staphylococcus aureus
Staphylococcus aureus causes intoxication via heat-stable enterotoxins that survive normal cooking. Foodborne pathogen testing in this category combines bacterial enumeration with direct enterotoxin immunoassay so heat-treated finished products can be cleared with confidence.
- AOAC 2003.07 / 2003.08
- Petrifilm™ / Plate Count
Sample Size: 50g | LOD: < 10 CFU/g | Shipping: Refrigerated (2–8°C)
Industry Application:Primary target for Ready-to-Eat (RTE) foods involving manual assembly — bakery fillings, cream pastries, dairy products, and hand-contact-surface monitoring.

Bacillus cereus
Bacillus cereus forms heat-resistant endospores that survive cooking and germinate in starchy foods held at improper temperatures. Spore-specific detection is critical for rice, pasta, dried ingredients, and powdered formulations.
- FDA BAM Chapter 14
- MYP Agar Plate
Sample Size: 50g | LOD: < 10 CFU/g | Shipping: Refrigerated or Ambient
Industry Application:Critical for starchy foods (rice, pasta, potatoes), dried milk powders, spices, and verification of cooling protocols in catering operations.

Clostridium spp.
Anaerobic foodborne pathogen testing for Clostridium perfringens and Clostridium botulinum is essential for vacuum-packed and reduced-oxygen-packaged (ROP) products. Detection in oxygen-deprived environments .
- FDA BAM Chapter 16
- Anaerobic Plate Count
Sample Size: 50g | LOD: < 10 CFU/g | Shipping: Refrigerated (2–8°C)
Industry Application:Vital for meat processors handling large roasts, stews, and gravies; sous-vide and ROP foods; required for low-acid canned food safety validation.

Campylobacter spp.
Campylobacter jejuni is the leading bacterial cause of gastroenteritis worldwide and the primary FSIS performance standard for poultry. Microaerophilic detection requires specialized handling.
- AOAC RI 031209
- PCR Molecular
Sample Size: 25g or rinse fluid | LOD: Negative/25g | Shipping: Refrigerated (do not freeze)
Industry Application:Primary FSIS performance standard for poultry processing (broilers, turkeys); compliance testing for raw milk; rinse-water and carcass-swab monitoring.
Vibrio spp.
Vibrio parahaemolyticus and V. vulnificus are halophilic marine pathogens responsible for severe shellfish-borne illness. Testing for raw oysters, clams, shrimp, and aquaculture exports .
- FDA BAM Chapter 9
- Culture / PCR
Sample Size: 50g | LOD: Negative/25g | Shipping: Refrigerated (2–8°C, do not freeze)
Industry Application:Mandatory for shellfish harvesters (oysters, clams), shrimp processors, and aquaculture export certification.

Shigella spp.
Shigella transmits via the fecal-oral route and is a primary outbreak target in food service. Rapid PCR detection identifies contamination from infected handlers, contaminated produce, or agricultural irrigation water.
- FDA BAM Chapter 6
- Culture / PCR
Sample Size: 25g | LOD: Negative/25g | Shipping: Refrigerated (2–8°C)
Industry Application:Primary target in outbreak investigations; routine screening for high-risk manual-assembly foods; testing of imported produce and agricultural water.
Industries at Risk for Foodborne Pathogens
Targeted foodborne pathogen testing for high-risk commodity groups, with foodborne pathogen testing protocols matched to each vertical.

Beef & Poultry

Seafood & Shellfish

Fresh Produce

Dairy & Cheese

Ready-to-Eat (RTE)

Spices & Dry Goods
Why Choose AGT Food Labs?
Single-point coordination, rapid turnaround, and expert support across every foodborne pathogen testing program we manage.
ISO/IEC 17025:2017 and FDA LAAF recognized. Your microbiological results are legally defensible.
PCR-based screening typically returns results in 24–48 hours; cultural confirmation adds 3–5 days for presumptive positives.
Direct access to technical managers for result interpretation, environmental monitoring plans, and corrective-action guidance.
Common Questions About Pathogen Testing
What are the "Big 4" foodborne pathogens?
How do you test for bacterial toxins in food?
What is STEC and why is it a zero-tolerance adulterant?
How long does foodborne pathogen testing take?
Can you test for viruses like Norovirus?
How much sample is required for pathogen testing?
Difference between Listeria species and Listeria monocytogenes testing?
Do you provide environmental monitoring swabs?
Related Safety & Stability Services
Complete your microbiological profile with these specialized testing solutions.
Salmonella Screening
Rapid molecular screening and cultural confirmation for Salmonella spp. in finished products and ingredients.
Listeria Detection
Targeted screening for Listeria spp. and L. monocytogenes confirmation for safety and facility hygiene.
Food Hygiene Indicators
Monitor general quality using APC, Coliforms, and Yeast & Mold to validate facility sanitation.
Prevent Foodborne Illness & Recalls
Verify your products are pathogen-free with our accredited foodborne pathogen testing using PCR and culture screening methods.
Request a Pathogen Quote